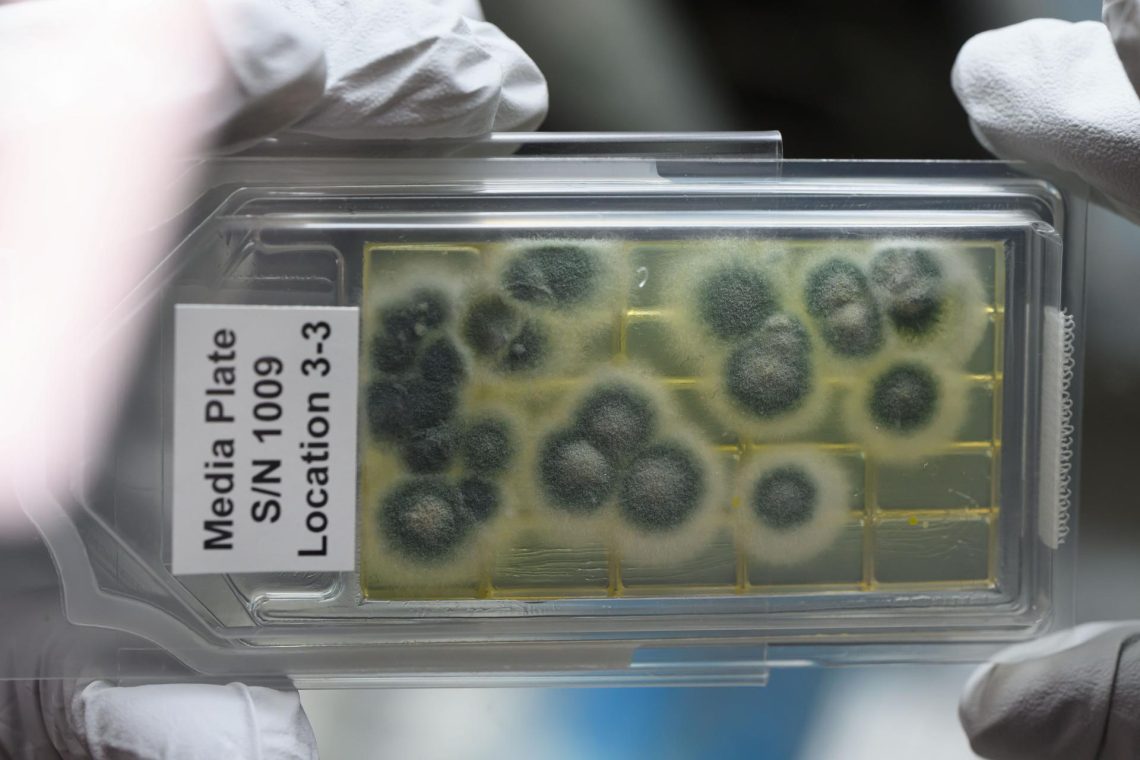
NASA experiments offer rare chance to report on health in a new space

Tag
antibiotic resistance
-
NASA experiments offer rare chance to report on health in a new space
NASA is conducting experiments in space on antibiotic-resistant bacteria, blood clotting and more with possible implications for health on Earth.

-
How is the U.S. preparing for the “second punch” of antibiotic resistance?
Journalists should check in on how the U.S. government and the nation’s hospitals and medical practices intend to regain ground…

-
Another brewing infectious disease threat and looking to COVID-19 for solutions
The threat of antibiotic resistance continues to grow in 2022. Reporters looking for new angles on how to cover this brewing…

-
Super bug threat potential rising with COVID-19
If you are looking for an undercovered story during this pandemic, take a look at the continued threat of antibiotic-resistant…

-
•
Dentists urged to reduce prescriptions of pre-treatment antibiotics
Across America, dentists write about 10% of all antibiotic prescriptions, data show, making them the top specialty prescribers of antibiotics…

-
How a journalist overcame challenges of covering antibiotic resistance
Since the dawn of antibiotics, there has been antibiotic resistance. Until about 20 years ago, this threat remained muted because…

-
Persistent threats to U.S. children’s health the focus of #AHCJ19 session
While measles may be the hot topic in the news at the moment for children’s health, it’s far from the…

-
Increasing infectious disease outbreaks highlight need for public health reporting
Deadly infectious disease outbreaks are occurring more often around the world. Influenza virus circulated in the southern hemisphere and then…

-
Tell stories about lab rats on the radio
A cup of coffee with a former journalist colleague led Rhode Island radio reporter Lynn Arditi down the path of…

-
In race between bugs and drugs, the bugs are pulling ahead
PHOENIX – To picture a future in which antibiotics no longer work, all we have to do is look at…